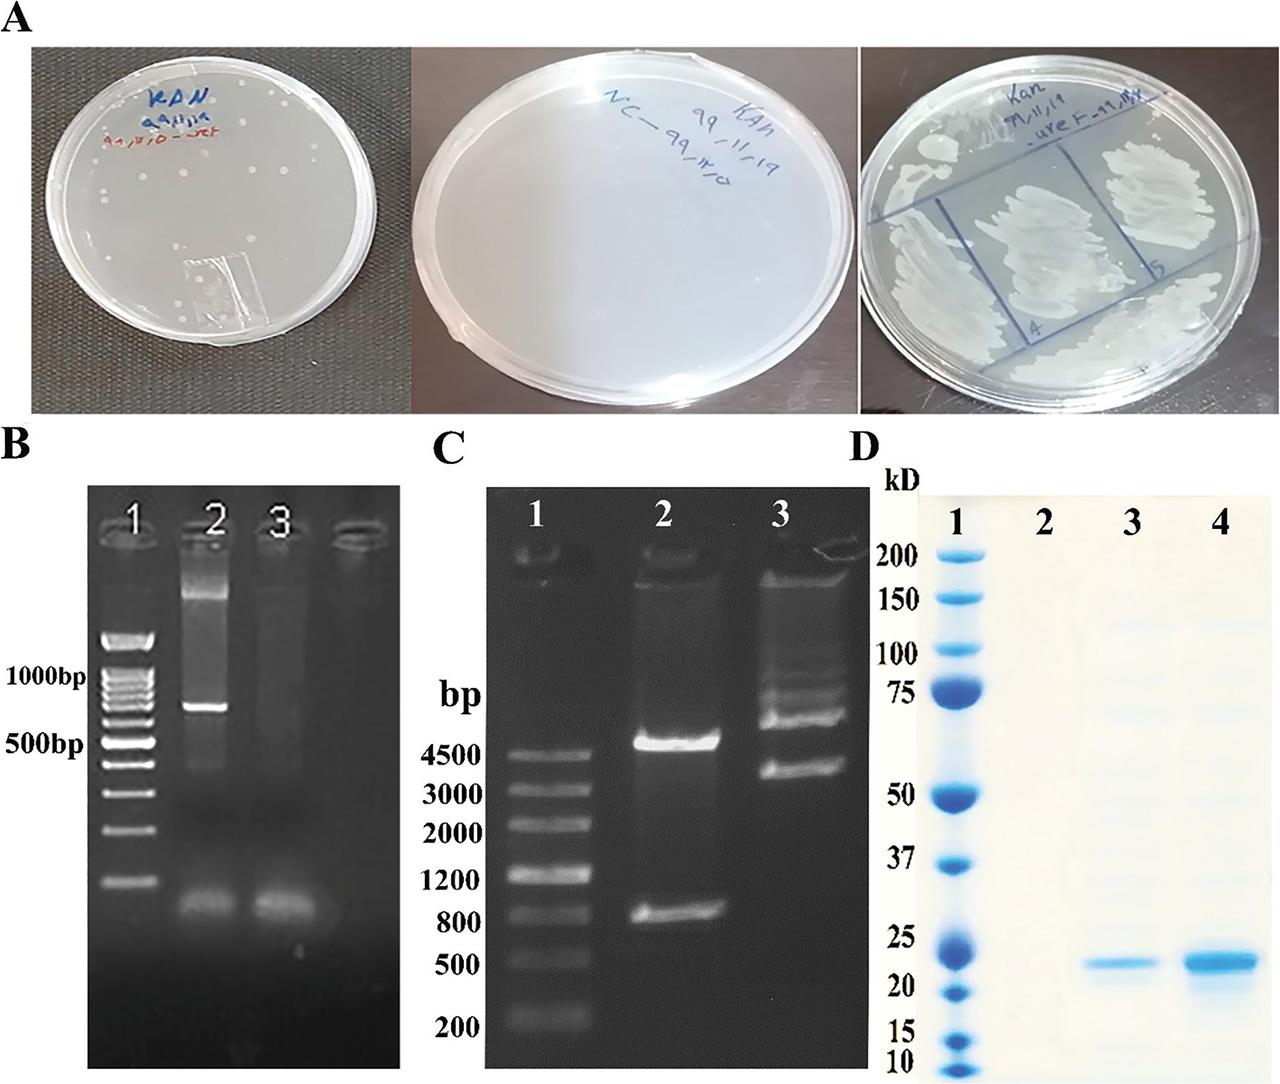

Gastric adenocarcinoma is the second most prevalent cancer-related cause of death globally, coming in at number four after lung, breast, and colorectal cancers, particularly in low- and middle-income nations like Asia (Ranjbar and Chehelgerdi 2018). morbidity and death rates are caused by gastric cancer (GC), and Helicobacter pylori (H. pylori) infection, a category one carcinogen according to the National Agency for Research on Cancer, is responsible for >80% of the global GC burden. The H. pylori strain strongly correlates with intestinal metaplasia and GC prevalence. The bacteria H. pylori, which lives in the stomach, causes chronic gastritis, the primary cause of most cases of GC (Chehelgerdi and Doosti 2020). Approximately, half of humanity is affected by the bacterium, a flagellar microaerophilic Gram-negative bacillus (O’Connor et al. 2020). In Western nations, the frequency of infections ranges 10–60%, but in underdeveloped nations, it can reach up to 90% during maturity (Mezmale et al. 2020).
In addition, research has revealed that the most common way that H. pylori infections are spread is from mother to child. This is especially true for young children under 5 years (Fakharian et al. 2022). H. pylori can colonize and remain in a particular biological niche inside the gastric lumen, where it may live in the acidic conditions of the stomach (Zhang et al. 2022). The helical structure of this human infection causes the bacteria to enter and stay in the stomach lining, behind the mucus, and it manages to evade the host immune system’s defenses (Kusters et al. 2006; Tilahun et al. 2022). According to several lines of evidence, H. pylori infections are linked to the etiology of chronic proximal gastroenteritis, chronic gastritis, and GC (Malfertheiner et al. 2022; Tempera et al. 2022). However, a combination of proton pump inhibitors and various antibiotic treatments is typically used to treat H. pylori pathogens. The rapid spread of antibiotic-resistant isolates and some observed side effects necessitate substituting such an expensive treatment with a different therapeutic strategy (Nagaraja and Eslick 2014). The majority of the H. pylori-associated pathogenicity factors have been identified, making the development of vaccines a potential strategy (Sharndama and Mba 2022).
Vaccines not only offer long-lasting defense, but also lessen the harmful effects of widespread antibiotic use on strains of H. pylori that are good for human health (Malfertheiner et al. 2022). However, H. pylori infection and serious problems can still occur in patients receiving pharmacological therapy for symptoms and those who are asymptomatic, and vaccinations may be able to solve this issue (Shatila and Thomas 2022). There have been significant efforts in recent years to increase the number of H. pylori vaccines based on the organism’s essential virulence factors, such as the flagellum receptors, vacuolating enterotoxin, cytotoxin-associated antigen, urease, the pathogenic organisms island, and neutrophil-activating protein, whether in their native or recombinant configurations. Although the associated processes remain unexplained, these methods protect the laboratory mouse model (Maleki Kakelar et al. 2019). Nowadays, possible H. pylori antigens encoded via vector-based vaccines have also been considered; however, the methods mentioned above have yet to shield the host from infection (Park et al. 2022).
Since DNA vaccines are generally safe and stable and generate cellular and humoral immunity, researchers have recently focused more on vector-based vaccinations than recombinant protein vaccines. Additionally, incorporating DNA encoding the pathogen’s antigen onto a bacterial plasmid may create these vaccines just as simply as polyvalent vaccinations (Maleki Kakelar et al. 2019). In this method, discovering the optimal vaccine against this prevalent human infection might arise from targeting conserved and essential genes of H. pylori to introduce in the vector (Kang et al. 2012; Xue et al. 2019). Studies now indicate that urease is a crucial element in the colonization of H. pylori in the host and the development of severe infection (Gupta et al. 2019). Urease is a potent immunogen that triggers a robust immune response and is essential for H. pylori metabolism and virulence. It is also required for the colonization of the gastric mucosa. This enzyme is a potential vaccine candidate for diagnosis, follow-up after therapy, and taxonomic identification. An intriguing paradigm for metallo-enzyme investigations is urease (Kafarski and Talma 2018). Prior to the identification of H. pylori, it was believed that humans produced “gastric urease.” It is now understood that this bacteria, which inhabits the human stomach mucosa, is the source of this noteworthy protein. According to the previous papers, the current study’s objectives were cloning and developing the H. pylori-derived urease gene encoding into the eukaryotic expression vector and assessing the immunomodulatory activity of such a recombinant construct in an animal model.
Invitrogen produced the pIRES2-DsRed-Express plasmid (Carlsbad, CA, USA). The human GC cell lines MKN28 and AGS, as well as the HEK 293-T cells, were bought from the Iranian Biological Resource Center (Iran) and cultured in DMEM (Hyclone, Logan, UT, USA) with 10% fetal bovine serum, 100 U/mL penicillin, and 100 mg/mL streptomycin (Sigma-Aldrich, USA). Female BALB/c mice that were 6 weeks old and normal and nude (nu/nu) were acquired from the Biotechnology Research Center of Islamic Azad University, Shahrekord branch (Shahrekord, Iran) and kept under specified pathogen-free conditions. The Biotechnology Research Center of Shahrekord Islamic Azad University’s Ethics Committee’s instructions for the correct use and care of laboratory animals were followed when conducting the animal research.
The BGI Genomics Company produced the ureF gene independently (Shenzhen, China). The ureF gene was subsequently inserted into the plasmids pIRES2-DsRed-Express (Invitrogen, USA) to generate pIRES2-DsRed-Express-ureF, which was verified by DNA sequencing and endonuclease digestion assays using BamHI (GGATCC) and EcoRV (GATATC). The constructs have 20 repeats of the CpG ODN C274 motif (5′- TCGTCGAACGTTCGAGATGAT -3′) and a Kozak nucleotide at the N-terminus to boost immunological response. Lipofectamine 2000 was used to transiently transfect the generated plasmids into HEK 293-T cells to confirm the eukaryotic expression vector (Invitrogen). After 48 h of transfection, the cells were collected and lysed. The total cellular proteins were then analyzed using a Western blot kit and a rabbit anti-H. pylori polyclonal antibody (pAb) from LifeSpan BioSciences in Seattle, Washington, USA, following the manufacturer’s instructions.
Randomly selected BALB/c mouse groups (Table S1 in Supplementary Material) received a DNA immunization (100 μg of plasmid) and an injection of the immunogen combination into the double hind thigh (0.3 mL per mouse). For three rounds, 0.3 mL of orbital blood was obtained from each of the animals (five per group), who had immunizations at days 0, 15, and 30. The empty vector served as the vehicle control, and orbit blood tests were also collected 2 weeks after the most recent vaccine. To make the single-cell suspensions, the animals’ spleens were removed after cervical dislocation sacrifice. Before separating and transferring the splenic T cells, the related immunological response was first ascertained using the splenic cells and blood samples.
The appropriate Mouse ELISA Quantitation Kit (Montgomery, USA) was used to measure the levels of IgG1 and IgG2a in the serum of vaccinated mice. Using mouse Quick EIATM kits, the quantities of interleukin (IL)-4, IL-17, interferon (IFN)-γ, and tumor necrosis factor (TNF)-α were measured using the double-antibody sandwich ELISA technique (Dakewe Biotech, China). Following the manufacturers’ suggested practices, each test was run twice.
The spleen and small intestine of the mice were removed under aseptic conditions and kept in liquid nitrogen at −198°C. Then, tissues were processed using the YTA kits’ instructions for RNA extraction and cDNA synthesis (Yekta Tajhiz, Iran). The GAPDH gene was utilized as an internal control during real-time PCR using the YTA SYBR Green master mix (Yekta Tajhiz, Iran). For real-time PCR, a reaction volume of 15 μL, composed of 0.5 μL cDNA, 0.5 μL forward primer, 0.5 μL rivers primer, 10 μL master mix, and 3.5 μL of double sterile distillation water, was employed. Primers are listed in Table 1. Along with initial denaturation for 10 min, the temperature cycle program also included 40 cycles at 95°C for 20 sec, annealing at 53°C for 1 min, and elongation at 72°C for 1 min, followed by the final elongation at 72°C for 10 min. The relative gene expression of IFN-γ, TNF-α, IL-17, and IL-4 were calculated by using the 2−ΔΔCT method and normalized to GAPDH levels in each sample.
Sequence of specific primers for real-time PCR reaction
| Gene | Size | Primer sequence |
|---|---|---|
| IFN-γ | 188 bp |
|
| IL4 | 263 bp |
|
| IL17 | 246 bp |
|
| GAPDH | 250 bp |
|
| ureF | 802 bp |
|
IFN, interferon; IL, interleukin.
The peripheral T-cell subpopulations were identified using flow cytometry in blood samples collected from each group’s immunized animals. Red blood cell (RBC) lysis was performed on 100 μL of fresh total blood under anticoagulation in 1× RBC Lysis Solution (eBioscience, USA). Following the manufacturer’s instructions, the company’s CD3e PE-Cy5, CD4 PE, and CD8a FITC antibody cocktail were used to stain the cell surface. The cells were cleaned before being examined using FlowJo 7.6.5 tools and an LSRII flow cytometer from BD Pharmingen in San Diego, California (Tree Star, USA).
Following the removal of the spleens from the vaccinated mice, single spleen cell suspensions were generated. Following the suggested methods, the MiniMACSTM Separator and Pan T Cell Purification Kit II (Miltenyi Biotec, USA) were utilized. By eliminating non-T cells such as B cells, natural killer (NK) cells, dendritic cells, macrophages, granulocytes, endothelium, and erythroid cells, pure CD3+ pan-T cells were generated. The extracted CD3+ T cells were submitted to flow cytometry using a combination of CD3e PE-Cy5, CD4 PE, and CD8a FITC antibodies from eBioscience in San Diego, California, and analyzed using FlowJo 7.6.5 software from Tree Star in the United States.
MTT analysis (Sangon Biotech, China) was used following the manufacturer’s instructions to evaluate the in vitro anti-cancer activity of H. pylori vaccine-activated CD3+ T cells. The effector cells were cocultured in 96-well plates with MKN28 and AGS cells for 24 h at a ratio of 1:25. The negative control was created using the splenic CD3+ T cells from the mice who had received the vehicle immunization. The following formula was utilized to determine the inhibitory efficiency of effector cells:
Three duplicates of each experiment were run.
With the aid of a CCK-8 detection kit, the CCK-8 assessment was completed (Dojindo Japan). Before the cell lines received the CCK-8 chemical treatment, the transfected cells were seeded into culture plates and grown for 10 h. 450 nm was used to measure absorbance.
Cancer cells were placed on a pre-coated plate with adherent cells in a 24-well transwell tube (Corning) (BD Biosciences, San Jose, CA, USA). After 24 h of treatment, the top surfaces were brushed, and the invaded regions were fixed with 4% paraformaldehyde and stained with Giemsa. Afterward, the optical microscope was used to observe the cells.
The H. pylori-activated CD3+ T cells were administered through adoptive transfusion to a nude BALB/c animal model with GC xenograft. Briefly, 1 × 107 MKN28 cells were injected into the right forelimb armpit of female mice 6 weeks old. Every 3 days for three rounds, 2 × 107 CD3+ T cells were infused into the caudal vein after the subcutaneous cancer nodules reached a size of roughly 100 mm3. Every 2 days, the tumor volume (V) was measured using calipers and computed using the formula: V = a b2/2, where a and b stand for the main and minor axes of cancer, respectively. Two weeks following the last T-cell infusion, the mice were killed by cervical dislocation, and the cancer nodules were excised and employed in later research.
The EnVision approach was used to use IHC to identify the subset of infiltrating immune cells in the tumor tissue sections. The segments were briefly cleaned with xylene, rehydrated with alcohol, and then cleaned once more with PBS. Anti-CD4 (Santa Cruz Biotechnology, USA), anti-CD8 (Santa Cruz, USA), anti-FOXP3 (Abgent, USA), anti-CD56 (Dako, USA), anti-CD68 (Dako, USA), anti-CD86 (Dako, USA), and anti-CD163 (Dako, USA) pAbs were incubated with the samples overnight at 4°C. After removing the main antibodies, Dako applied the Envision-plus detecting system’s components. Hematoxylin was used as a counterstain, and an aqueous mounting media was used as a cover slip. Optical microscopy was used to evaluate the slides, and the positive index was derived using the ratio of stained cells.
Following adoptive transfusions of CD3+ T cells, a Western blot analysis was done to identify apoptosis and antiapoptosis mechanisms in the GC xenograft. Following 12% SDS-PAGE separation and electrophoretically transfer to PVDF membranes, identical quantities of molecules from the tumor tissues were isolated. After the membranes had been blocked with 5% non-fat milk, individuals were probed with specific antibodies, including anti-Survivin rabbit polyclonal antibodies from Santa Cruz Biotechnology, anti-Caspase 9 mouse monoclonal antibodies from Cell Signaling Technology in Beverly, Massachusetts, and anti-Cleaved Caspase 3 mouse monoclonal antibodies (Cell Signaling Technology, 1:1000). The immunoreactive patterns were detected by enhanced chemiluminescence on the SuperSignal substrate platform (Rockford, USA) after the membranes had been washed and treated with HRP-conjugated goat anti-rabbit/mouse IgG (Cell Signaling Technology, 1:20,000).
Every study was conducted twice, and the data were presented as mean ± SD. The group variations were examined using one-way ANOVA and independent variables t-tests. The analysis was done with SPSS software, and the graphics were made with Graph-Pad Prism. A P-value of <0.05 was used to indicate significance.
The ureF gene was inserted into the eukaryotic expression vector pIRES2-DsRed-Express to construct the DNA vaccine structure depicted in Figure S1 in Supplementary Material. The recombinant plasmid’s genetic composition was used to measure the success of the cloning process. Moreover, DNA examination revealed that the virulence gene sequence of the recombinant plasmid was 100% similar to that of the H. pylori bacteria (Figure S2 in Supplementary Material). The generated plasmid was digested with BamHI and EcoRV. Single colonies of transformed bacteria containing a plasmid with ureF gene are shown in Figure S3 in Supplementary Material. The effectiveness of the recombinant plasmid synthesis was shown by electrophoretic separation of the digestion fragments around 802 bp, encoding the ureF gene (Figures 1a and 1b). Blast was used to look over the recombinant plasmid sequencing outcomes. Recombinant plasmids with an E-value of 8e-94 and Per.Ident was 98.57%, similar to the target bacterium. The expression of target proteins encoded by relevant inserted genes is confirmed by Western blotting assay after the recombinant vector is reversibly transfected into HEK 293-T cells (Figure 1c). The plasmid vaccines containing the aforementioned H. pylori ureF gene fragments have thus been effectively created.
(A) Single colonies of transformed bacteria containing plasmid with uref gene; Non-growth of vector-free cells in agar medium containing the antibiotic kanamycin (negative control); Preparation of matrix from a number of selected colonies. (B) Validation of 805 base pairs of ureF gene in H. pylori genome by PCR test, 1: DNA markerIII, 2: 805 base pairs of ureF gene, 3: Negative control; (C) the successful production of the recombinant plasmid. 1: DNA markerIII, 2: recombinant pIRES2-DsRed-Express-ureF before digestion, 3: recombinant pIRES2-DsRed-Express-ureF after digestion; (D) Expression of recombinant pIRES2-DsRed-Express-ureF in protein level. 1: Protein marker, 2: Negative control; 3 and 4: pIRES2-DsRed-Express-ureF.
The effectiveness and subtypes of the corresponding immune function are assessed after administering all recombinant H. pylori DNA vaccines to BALB/c mice. The concentrations of IL-4, IL-17, IFN-γ, and TNF-α in the blood of vaccinated mice were also detected using the ELISA. The IgG1 and IgG2a concentrations noticeably increased by 1900 ng/mL to 3900 ng/mL and 4300 ng/mL to 6900 ng/mL, respectively, after the last vaccination in the vaccinated groups. IgG1/IgG2a ratio dropped from 2.26 to 1.76 fold after receiving H. pylori DNA vaccinations, showing that DNA vaccines were more effective at eliciting an IgG2a response (Figure 2a).

An analysis of the immunological responses and suppressive effects of splenic T-cells induced by H. pylori DNA immunizations. (A) ELISA measured serum IgG1 and IgG2a concentrations in several groups of vaccinated mice. (B) ELISA measurements of TNF-α, IFN-γ, IL-4, and IL-17 relative levels and concentrations in different mouse immunization groups. *P<0.05, **P<0.01, ***P<0.001 and ns: not significant.
In the pIRES2-DsRed-Express-ureF group, the levels of IL-4 and IFN-γ in the blood dropped from 2800 ng/mL to 250 ng/mL and 3500 ng/mL to 980 ng/mL, respectively. The concentration of TNF-α and IL-17 in the pIRES2-DsRed-Express-ureF group increased significantly. So the concentration of TNF-α increased from 2500 ng/mL to 7870 ng/mL (three folds), and the concentration of IL-17 increased from 1800 ng/mL to 19,800 ng/mL (11 folds). However, there are no appreciable increases in IL-4 serum levels across all groups (Figure 2). The primary immune reaction subtype is probably a combined pattern of T helper (Th)1 and 2 cells, but with polarization to the Th2 profile after vaccination, according to the IgG1 and IgG2a reactions and dynamic changes in cytokine levels (Figure 2).
The quantity of cytokine transcription in the spleen and small intestine was assessed using a quantitative real-time PCR technique. In the spleen of pIRES2-DsRed-Express-ureF vaccination groups, the IL-17 and TNF-α transcription levels were significantly higher than those in other groups (Figure 3a). Also, in small intestine tissue, real-time PCR findings from the pIRES2-DsRed-Express-ureF vaccination groups showed significantly different levels of IL-17 and TNF-α gene expression from the other groups, and these results were also consistent with ELISA (Figure 3b). IL-4 and IFN-γ transcription levels were not considerably different in the pIRES2-DsRed-Express-ureF group and other groups. After the final immunization, blood samples from the animals were obtained and submitted to flow cytometry to determine the peripheral T-cell subpopulations. The DNA vaccines, except for the pIRES2-DsRed-Express-ureF group, increase the proportions of CD3+, CD4+, and CD8+ T-cell subgroups in the inoculated mice compared to the other group. As a result, the H. pylori DNA vaccine stimulates the Th cell response and changes the Th1 pro-inflammatory response into the Th2 anti-inflammatory reaction. This imitates the immunological state of animals with chronic H. pylori infection while encouraging TNF-α production and T-cell proliferation (Figure 3c).

Cytokine levels were found in the small intestine (A) and spleen (B) of the control and immunized groups. (C) Peripheral CD3+, CD4+, and CD8+ T-cell subpopulations in vaccinated mice were analyzed by flow cytometry. The immunization against pIRES2-DsRed-Express-ureF suppresses the invasion and growth of cancerous cells in the culture. (D) The MTT test examined the growth indices of three groups of AGS and MKN28 cells. Compared to the control group, the growth rate in the pIRES2-DsRed-Express-ureF group was considerably reduced. (E) Cell cycle regulation in cells was investigated using flow cytometry. Compared to the control group, the pIRES2-DsRed-Express-ureF vaccination group showed an increase in G0/G1 reduction in the proportion of the S phase to the G2/M phase. (F) The proportion of apoptotic cells was higher in the pIRES2-DsRed-Express-ureF vaccination group. *P<0.05, **P<0.01, and ns: not significant.
The impact of pIRES2-DsRed-Express-ureF vaccination on AGS and MKN28 cell proliferation was assessed using MTT. All pIRES2-DsRed-Express-ureF vaccine groups showed a substantial reduction in the growth rate of AGS and MKN28 cancer cells (P < 0.001), and there was a significant variation between the growth percentages of the control and pIRES2-DsRed-Express-ureF vaccine groups (Figure 4a). An Annexin V-PI staining procedure was utilized to look at any differences in apoptosis between the experimental groups. Accelerated cell proliferation was related to cell cycle progression. Cell cycle control in the groups that had received vaccinations was investigated using flow cytometry. Compared to the control groups, pIRES2-DsRed-Express-ureF-vaccinated cells had higher G0/G1 and lowered S phase to G2.M phase ratios. These results showed that pIRES2-DsRed-Express-ureF vaccination prevented cell cycle progression (Figure 4b). The ratios of early, late, necrotic, and surviving cells are shown in Figures 4c and d. The percentage of necrosis, late apoptosis, and early apoptosis in the control cells was <10%. Over 90% of the rates in control groups had viable cells. In AGS cells, the apoptosis percentages for pIRES2-DsRed-Express-ureF and pIRES2-DsRed-Express were 57.18% and 17.18%, respectively. In MKN28 cells, pIRES2-DsRed-Express-ureF and pIRES2-DsRed-Express triggered 54.82% and 12.12% apoptosis (Figures 4c and d).

The immunization against pIRES2-DsRed-Express-ureF suppresses the invasion and growth of cancerous cells in the culture. (A) According to a flow cytometry experiment, pIRES2-DsRed-Express-ureF caused 54.82 and 57.18% of AGS and MKN28 cells to undergo apoptosis, respectively. (B,C) The colony formation assay using pIRES2-DsRed-Express-ureF transfected AGS and MKN28 cells revealed that they proliferated. (D,E) The quantity of invading AGS and MKN28 cells. *P<0.05, **P<0.01, ***P<0.001 and ns, not significant.
AGS and MKN28 cell proliferation was decreased by pIRES2-DsRed-Express-ureF vaccination, as shown by colony formation assay and CCK-8 test (Figures 4e and f). According to the transwell invasion test analysis, the pIRES2-DsRed-Express-ureF vaccination decreased the amount of invading AGS and MKN28 cells, while control groups had the opposite impact (Figures 4g and h). As a result, in vitro immunization using pIRES2-DsRed-Express-ureF prevented AGS and MKN28 malignant cells from proliferating and invading.
Immunomagnetic beads were utilized to separate the H. pylori pIRES2-DsRed-Express-ureF vaccine from the inoculated mice. These effector cells were co-cultured with two different types of GC cells (the MKN28 and AGS cell lines) to confirm the in vitro anticancer impact. Since GC and H. pylori infection are closely related, different CD3+ T lymphocytes were mixed in equal amounts. In vitro co-cultures of CD3+ T cells of various compositions are performed with the MKN28 and AGS cell lines. Figure 5a shows that pIRES2-DsRed-Express-ureF immunotherapy groups had more potent inhibitory effects in both GC cell lines when compared to the control (P < 0.01). The most considerable inhibitory effects on MKN28 (81.6 ± 1.3%) and AGS (88.9 ± 2.3%) cells are shown by the combined CD3+ T cells from the target group. Additionally, the CD3+ T cells from the pIRES2-DsRed-Express-ureF group significantly inhibit cancer growth in the two GC cell lines.

Splenic T-cells stimulated by H. pylori vaccinations have anticancer effects in vivo and in vitro. (A) The inhibition percentages of H. pylori-activated splenic T-cells on in vitro-cultured AGS and MKN28 cell lines. (B) Splenic T-cells stimulated by H. pylori vaccinations have anticancer effects in vivo. Mouse body weight variation curves from day 0 to day 15 after adoptive infusions. (C) Tumor nodule size curves in animals from 0 to 15 days following T-cell infusions. (D) The mean weights of the mouse tumor nodules that were excised. (E) The levels of tumor inhibition in the various experimental groups. *P<0.05, **P<0.01, and ns: not significant.
The BALB/c mice are transfused with adoptive CD3+ T cells after being overburdened with GC cells. Compared to the PBS control, tumor growth is inhibited in the immunotherapy treatments with increased tumor necrosis and decreased tumor size and weight (Figure 5b). The mice’ body weight did not differ considerably across the groups (Figure 6a). Early on day 9 following CD3+ T-cell transfer, the tumor size changed, indicating the anti-GC impacts of the H. pylori vaccine-activated T cells. These effects persisted for at least another week (Figure 6b). When compared to the control group, the tumor volume in the pIRES2-DsRed-Express-ureF group has significantly decreased (Figure 6c). According to the changes in tumor size at day 15, the average tumor suppression rates for the pIRES2-DsRed-Express-ureF, pIRES2-DsRed-Express, and PBS groups were 82.3%, 20.1%, 5.2%, and 35.8%, respectively (Figure 6d). The findings indicate that GC development in vivo may be successfully inhibited by adoptively transferred CD3+ T cells stimulated by the H. pylori pIRES2-DsRed-Express-ureF DNA vaccine.

Evaluation of the xenograft tumor’s infiltrating immune cell subpopulations following adoptive T-cell infusions. (A) Illustration of CD4+ and CD8+ T cell invasion using representative staining, 20X magnification. (B) Positive T cell infiltration index and CD8+/CD4+ ratios in different groups. (C) Representative stains showing infiltrating CD68+ macrophages and FOXP3+ T cells, 20x magnification. (D) The FOXP3+ T cell and penetrated CD68+ macrophage infiltration positivity index. (E) Representative staining of the CD56+ NK lymphocytes and CD86+ M1 macrophages invaded, 20x magnification. (F) Positive infiltration index for CD56+ NK cells and CD86+ M1 macrophages. *P<0.05, **P<0.01, and ns: not significant.
IHC was used to analyze the subtypes of infiltrated CD3+, CD4+, and CD8+ T cells in the intramuscular xenograft of GC. The positive index and the tumor-infiltrating CD4+ T-cell concentrations in all treatment groups reveal lower levels (P < 0.01) (Figure 7a). However, adoptive infusions of the H. pylori DNA immunization CD3+ T cells have little effect on the infiltration of CD8+ T cells in the malignant tissues. In line with this, the ratios of infiltrating CD8+/CD4+ T cells rise dramatically across the board for all immunotherapy groups (Figure 7b). Additionally, compared to the PBS control, labeling of the regulating FOXP3+ T (Treg) lymphocytes in the pIRES2-DsRed-Express-ureF group is lower (Figures 7c and d). Notably, neither the proportions of infiltrating CD86+ macrophages nor the infiltrations of CD68+ macrophages (Figures 7c and d), CD86+ M1 macrophages (Figures 7e and f), CD56+ NK cells (Figures 7e and f), or CD68+ macrophages, indicate significant alterations.

(A) Illustration of CD4+ and CD8+ T cell invasion using representative staining, 20X magnification. (B) Caspase-9, Caspase-8, Cleaved Caspase-3, and Survivin signals in the xenograft tumor following adoptive T-cell infusions were examined by Western blot analysis. L1: Procaspase-9 (51 kDa); L2: Cleaved Caspase-9 (37 kDa); L3: Caspase-8 (57 kDa); L4: Cleaved Caspase-3 (17 kDa); L5: Survivin (16 kDa); L6: Negative control; M: Protein ladder. (C) L1-L6: GAPDH (20 kDa). *P<0.05, **P<0.01, and ns, not significant.
Several essential signaling molecules that are strongly connected with the apoptosis and anti-apoptosis mechanisms in GC are identified by Western blotting to recognize further the molecular intermediaries implicated in the anticancer activity of adoptive immunotherapy using the H. pylori pIRES2-DsRed-Express-ureF vaccine. Comparatively, to the controls, Survivin is considerably down-regulated in all pIRES2-DsRed-Express-ureF groups. Caspase-9 and Caspase-3 were dramatically upregulated in the cpIRES2-DsRed-Express-ureF group. Infusion of the H. pylori pIRES2-DsRed-Express-ureF DNA vaccine has no discernible effect on Caspase-8 expression (Figure 8), indicating that upregulation of Caspase-9/Caspase-3 and downregulation of Survivin following adoptive transfusions of the H. pylori pIRES2-DsRed-Express-ureF vaccine may improve cellular apoptosis.

Caspase-9, Caspase-8, Cleaved Caspase-3, and Survivin signals in the xenograft tumor following adoptive T-cell infusions were examined by Western blot analysis. 1: Procaspase-9 (51 kDa); 2: Cleaved Caspase-9 (37 kDa); 3: Caspase-8 (57 kDa); 4: Cleaved Caspase-3 (17 kDa); 5: Survivin (16 kDa); 6: Negative control; M: Protein ladder. GAPDH (20 kDa).
Clinical studies demonstrate that regardless of whether they have surgery, GC individuals with positive H. pylori infection tend to fare better than those with harmful H. pylori infection. After the microorganisms have first caused carcinogenesis, the H. pylori-induced immune reaction and chronic infection state may positively influence the development and prognosis of GC (Choi et al. 2012; Xue et al. 2019). This study aims to confirm this notion and investigate any related molecular pathways. Previous research using univariate analysis found a link between seronegative H. pylori status and poor outcomes in GC patients (Lee et al. 1995). In addition, two significant prospective studies (Meimarakis et al. 2006; Marrelli et al. 2009) demonstrated the predictive value of positive H. pylori status for prolonged relapse-free surviving (RFS) and overall surviving (OS) in curatively excised GC. These studies show that the median RFS and OS for patients with H. pylori-GC are 57 months and 62 months, respectively, as opposed to 19 months and 20 months for patients without H. pylori-GC. Patients with H. pylori-GC and those without it had 5-year survival rates of 57.0% and 24.0%, respectively (Meimarakis et al. 2006; Marrelli et al. 2009). Some retrospective investigations support the importance of the presence of H. pylori as a helpful predictive factor, whereas others do not (Li et al. 2013; Kolb et al. 2017).
The pooled relative risk for OS in patient populations with H. pylori-GC compared to those with non-H. pylori-GC is 0.71 (95% CI: 0.57–0.87; P = 0.001), as demonstrated by the meta-analysis of 12 studies involving 2454 sick people. This finding suggests that H. pylori infection plays a defensive function in the prognosis of GC (Wang et al. 2013). Additionally, in the later stages, individuals with H. pylori-GC had longer median OS and a more significant response to chemotherapy than patients without H. pylori-GC (Choi et al. 2012).
The causes of the disparate outcomes between H. pylori-GC and non-H. pylori-GC individuals are yet unknown. Some researchers have hypothesized that the increased microsatellite instability brought on by H. pylori infection may enhance the prognosis of GC (Kim et al. 2016; Piri-Gharaghie et al. 2022c). Additionally, H. pylori infection has been shown to inhibit constitutive production of the monocyte migration inhibitory factor, a possible risk factor for poor survival rates and advanced tumor phases in GC (He et al. 2015). Anti-urease antibodies may facilitate the death and even limit the spreading of cancerous cells in an autoimmune response because urease mimics and binds to specific ligands or surface proteins on gastric epithelial cells and platelets (Scopel-Guerra et al. 2017). Along with increasing the ability to promote antigen processing and presentation, T-cell stimulation and proliferation, and improved antitumor reaction, H. pylori infection stimulates monocytes, macrophages, and dendritic cells. Furthermore, it has been suggested that H. pylori-GC may boost the anticancer immune reaction (Larussa et al. 2015).
Here, DNA vaccines targeting the primary virulence genes (ureF) of H. pylori are developed and utilized to immunize mice against H. pylori-GC. To guarantee good imitation, many techniques are used (Piri-Gharaghie et al. 2022a, 2022b). First, DNA vaccines containing the ureF gene are introduced into a vector to prevent product toxicity. Second, to assess the kind and potency of the immune response brought on by the H. pylori vaccines, both the IgG subclasses and the Th1 and Th2 reactions are dynamically assessed after vaccination. ureF is only one of several H. pylori virulence factors that might cause the development of related antibodies. However, compared to the humoral immune reaction by B cells, the T-cell response often has a more significant anticancer effect. Since H. pylori infection is most directly related to the development of GC, the splenic CD3+ T cells generated by DNA vaccines are categorized and employed for adoptive transfusion to simulate that immunological condition.
A Th1-type response is often induced by acute H. pylori infection. It is primarily responsible for the increased release of IFN-γ, which causes severe inflammation and cellular damage in the stomach. Despite some contradicting results on the allegedly protective effect of the Th1 reaction, the Th2 response suppresses gastritis generated by pro-inflammatory cytokines and regulates H. pylori infection, showing the favorable involvement of the Th2 response in avoiding H. pylori-related illnesses (Wang et al. 2007; Xue et al. 2019). Although polarization from the Th1 to Th2 responses has a more significant role during chronic infection, carcinogenesis, and the development of H. pylori-GC, the Th1-biased immune reaction is known to be produced early by H. pylori infection. Previous identification in H. pylori-GC patients supports the growth tendency of IL-4 and IL-10 secretion and the lowering trend of the IgG1/IgG2a proportion (Wang et al. 2007; Xue et al. 2019).
As a result, DNA vaccination causes a switch from Th1 to Th2 responses, which closely resembles the host’s shifting immunological state in GC with persistent H. pylori infection. In order to imitate the changes in TNF expression brought on by H. pylori infection in patients with chronic gastroenteritis, intestinal metaplasia, dysplasia, and GC, the raised TNF level is seen following vaccination (Martínez-Becerra et al. 2012; Ghajari et al. 2021). Additionally, H. pylori DNA vaccines cause regional CD3+CD4+ and CD3+CD8+ T lymphocytes to proliferate significantly in mice. This increased proliferation and the effector functions of stimulated CD3+ T cells likely reduce tumor development and improve the prognosis for H. pylori-GC. In a mouse model with tumors, the vaccine-activated splenic CD3+ T cells are separated, co-cultured with GC cell lines, and given adoptive transfusions. The mean tumor inhibition percentages are 35.8–72.3% in vivo and 77.6–4.7% in vitro, confirming the anticancer activity of the H. pylori pIRES2-DsRed-Express-ureF vaccine.
Several pathways have been proposed to explain the anti-GC functions of CD3+ T lymphocytes generated by H. pylori vaccinations. Investigations have been made on the modifications in the immune response of the infiltrating T-cell sub-populations (van den Engel et al. 2006; Xue et al. 2019). In this research, adoptive T-cell transfusions resulted in a considerable reduction in the infiltration of CD4+ T cells while leaving little to no change in the infiltration of CD8+ T cells, CD56+ NK cells, CD68+ monocytes, or CD86+ M1 macrophages. Accordingly, the proportions of the infiltrating CD8+/CD4+ T cells rise, indicating that CD8+ T-cell-dominated polarization is generated and that the particular antitumor actions help improve prognosis. The identification and interaction between antigens and T cell ligands also play a crucial role in T cells’ proliferation and anticancer actions (TCRs). Therefore, it may be assumed that the previously described cross-reaction among GC and H. pylori proteins exists. Enhanced cancer cell death by the homed-activated lymphocytes may potentially be caused by an autoimmune pathway, although further research is required to confirm this (Baldari et al. 2005; Xue et al. 2019). The FOXP3+ Treg cells, which can block a range of immunological responses, are crucial intermediaries of tumor cell tolerance (Shen et al. 2010).
Since adoptive immunotherapy reduces the percentages of FOXP3+ T cells in this research, transfusion of CD3+ T cells triggered by the H. pylori vaccinations likely lowers the growth or infiltration of Treg cells and, consequently, the Treg-induced immunological tolerance as well (Zhang et al. 2014). Additionally, apoptosis is encouraged following CD3+ T-cell transfusion, probably due to an increase in Caspase-9/Caspase3 and a decrease in Survivin, two factors strongly related to the development, infiltration, and migration of GC (Li et al. 2017).
The DNA vaccines presented here differ from most previously reported vaccinations used to prevent infection since they are deliberately designed to imitate the immunological status generated by chronic H. pylori infection. This is done to overcome the limitations. Although they may not provide the highest immunological response, our vaccines and combination vaccination techniques are explicitly developed for this reason. To study how the H. pylori-induced T cell reactions affect the development of GC, activated CD3+ T cells are infused into GC-bearing mice models. It is not comparable to the more challenging condition of a naturally occurring H. pylori-GC. Therefore, further research is required to examine the host as well as the immunogens of H. pylori. To confirm the molecular basis of the particular anticancer actions of activated T cells, it is first necessary to identify the TCR gene spectrum of lymphocytes infiltrated by tumors and compare it to the epitope patterns of H. pylori proteins. In order to rebuild and clarify the natural impacts of the H. pylori-related immune function on the prognosis of GC, a conventional mouse model with primary H. pylori-GC should be produced, although with challenges.